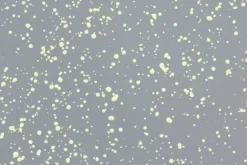
Hem Last stool, grey - lime splatter

Hem’s Last stool captivates with its distinctive expression. Crafted from enameled metal, the stool is extremely durable and stable, yet easy to lift and move around due to the handy indentation. The Last stool, designed by Max Lamb, is a versatile piece equally impressive at a dining table or as a nightstand or side table. Besides, it also works as a guaranteed conversation starter. The hand-splattered design makes every stool a unique piece of art.
Be the first to review “Hem Last stool, grey – lime splatter” Cancel reply
Related products
$126.99
Sale!
Sale!
$128.99
Sale!
Furniture
$130.99
Sale!
Furniture
Sale!
Sale!
$126.99
Furniture
$122.99
Sale!
Sale!
Sale!
$126.99
$136.99

Reviews
There are no reviews yet.